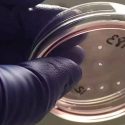

redes
-

Lego trolea a Tesla en redes, se burla de su Cybertruck
Llevábamos meses esperando el anuncio de la primera pickup de Tesla, una camioneta que no solo nos sorprendió por el precio, sino también por su…
-

Así usa Youtube las redes neuronales para elegir qué contenidos te recomienda ver a continuación
Uno de los usos más comunes de la tecnología de aprendizaje automático son los sistemas de recomendación de las plataformas online: cada vez que Facebook…
-

Descifran el mecanismo celular que provoca la esquizofrenia
La esquizofrenia es un trastorno psiquiátrico que afecta a alrededor del 1% de la población mundial. Sus síntomas (lenguaje y pensamientos desorganizados, delirios, alucinaciones, trastornos…
-

Investigadores descubren cómo imprimir redes vasculares en 3D
El campo de la ingeniería de tejidos ha visto un gran progreso, ya que se están desarrollando complejos sistemas 3D que ofrecen fuerza, contienen múltiples…
-

Las redes inalámbricas globales de 5G ponen en peligro los pronósticos meteorológicos
El Gobierno de Estados Unidos ha puesto ya en marcha la subasta de las frecuencias de radio para comunicaciones inalámbricas que utilizará la próxima generación…
-

El MIT desarrolla un sistema para entrenar redes neuronales en tiempo récord
En el momento de nacer, el ser humano tiene aproximadamente 100.000 millones de neuronas, que apenas se relacionan entre ellas. Gracias a los estímulos que…
-

MIT crea algoritmo que aumenta la velocidad de entrenamiento de redes neuronales
Las redes neuronales representan uno de los avances tecnológicos más importantes de nuestros tiempos, sin embargo, encontrar una manera más eficiente de desarrollar uno de…
-

Una pistola de rayos X identifica la carga en un antiguo naufragio
Arqueólogos han logrado averiguar de dónde provenía originalmente el cargamento cerámico de un navió hundido hace unos 800 años en el mar de Java, mediante…